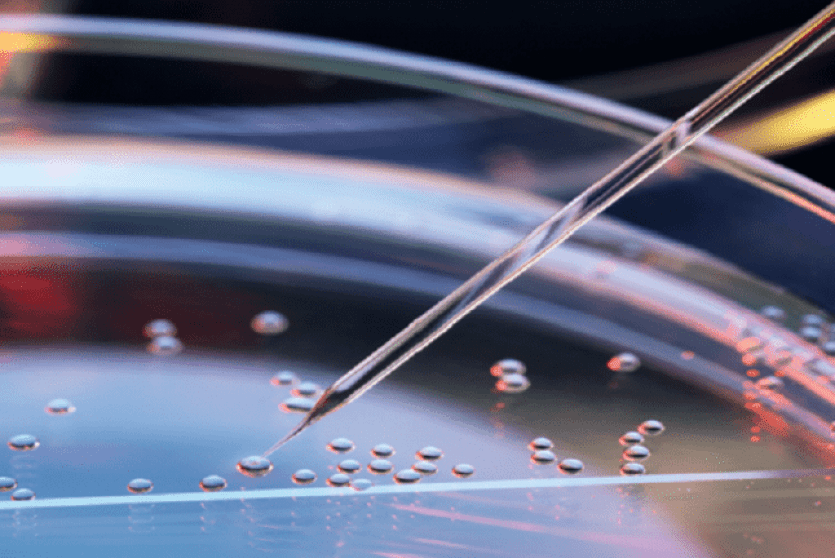
علماء ينجحون في إنشاء مزيج خيالي من خلايا البشر والقردة

علماء ينجحون في إنشاء مزيج خيالي من خلايا البشر والقردة
نجح علماء في تجربة رائدة ومثيرة للجدل، في إنشاء مزيج خيمري خيالي من خلايا البشر والقردة، تتواجد معا في جنين حي لم يكن من الممكن أن تتخيله الطبيعة لولا ذلك.
وفي حين أن البحث في الأنواع الهجينة بين الإنسان والحيوان له تاريخ طويل ومشكوك فيه، فقد سعى الباحثون في السنوات الأخيرة إلى اتباع كائنات خيمرية (حيوان يمتلك تجمعين أو أكثر من الخلايا المتميزة جينيا) لاستقصاء أسئلة علم الأحياء التي من شأنها أن تقدم مكاسب كبيرة في مجالات مثل الطب التجديدي.
وعلى سبيل المثال، إذا كنا قادرين بطريقة ما على إتقان نمو الأعضاء البشرية في أنسجة الخنازير، فقد نقطع شوطا طويلا لحل النقص الهائل في الأعضاء الذي يكلف حياة الإنسان كل يوم، وفق روسيا اليوم.
ولهذه الغاية، تصدّر فريق بقيادة خبير التعبير الجيني، خوان كارلوس إيزبيسوا بيلمونتي، من معهد Salk في كاليفورنيا، عناوين الصحف في عام 2017، حيث أنشأ أول جنين هجين من خنزير-إنسان، بهدف التمكن يوما ما من إنتاج أعضاء بشرية قابلة للزرع من الحيوانات.
وكما حدث في تجارب مماثلة مع هجينة من الأغنام والبشر، كانت كمية الخلايا البشرية المدمجة بنجاح منخفضة جدا، ما يشير إلى بعض أوجه عدم التوافق بين الخنازير وبيولوجيا الإنسان على المستوى الجزيئي.


